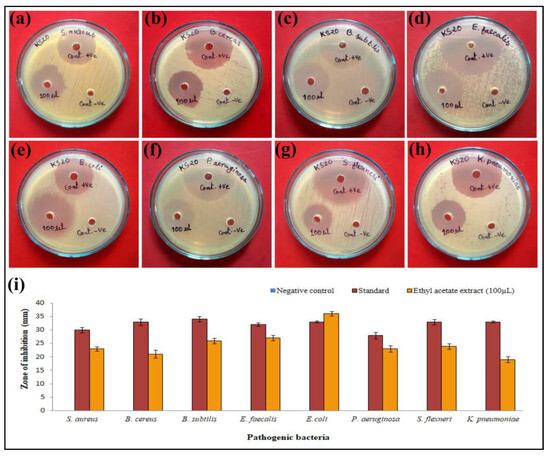
Unveiling the Pharmacological Significance of Marine Streptomyces ...

Ks20 And/or
Promote sustainability through substantial collections of eco-focused Ks20 And/or photographs. ecologically highlighting photography, images, and pictures. designed to promote environmental awareness. Browse our premium Ks20 And/or gallery featuring professionally curated photographs. Suitable for various applications including web design, social media, personal projects, and digital content creation All Ks20 And/or images are available in high resolution with professional-grade quality, optimized for both digital and print applications, and include comprehensive metadata for easy organization and usage. Explore the versatility of our Ks20 And/or collection for various creative and professional projects. Professional licensing options accommodate both commercial and educational usage requirements. Whether for commercial projects or personal use, our Ks20 And/or collection delivers consistent excellence. Comprehensive tagging systems facilitate quick discovery of relevant Ks20 And/or content. Time-saving browsing features help users locate ideal Ks20 And/or images quickly. Reliable customer support ensures smooth experience throughout the Ks20 And/or selection process. The Ks20 And/or collection represents years of careful curation and professional standards. Cost-effective licensing makes professional Ks20 And/or photography accessible to all budgets. Diverse style options within the Ks20 And/or collection suit various aesthetic preferences. Regular updates keep the Ks20 And/or collection current with contemporary trends and styles.